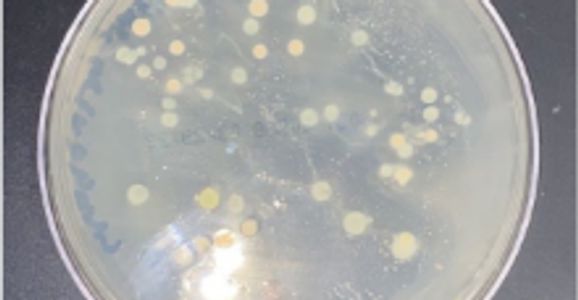

Signed in as:
filler@godaddy.com
Signed in as:
filler@godaddy.com
Because some people were skeptical as to whether or not ultraviolet technology worked, UV•PC devised an experiment to prove the effectiveness of UV lights. We swabbed three different phones and allowed the bacteria to fester for a few days. We put those three phones in our prototype for different time intervals to determine. Our finds our shown below. All the yellow dots are bacteria colonies such as E. coli. As you can see, our device makes a huge impact on the cleanliness of your phone after even just a minute of usage.






We wanted to compare the different current solutions that females use to store their phones in bathrooms, we swabbed these solutions and let the bacteria fester. All the yellow dots are bacteria colonies such as E. coli. As you can see, they are incredibly dirty and unsanitary and by placing your phone there, the bacteria spreads to your phone and could cause you to get sick.

UV•PC
Copyright © 2024 UV•PC - All Rights Reserved.
Powered by GoDaddy
We use cookies to analyze website traffic and optimize your website experience. By accepting our use of cookies, your data will be aggregated with all other user data.